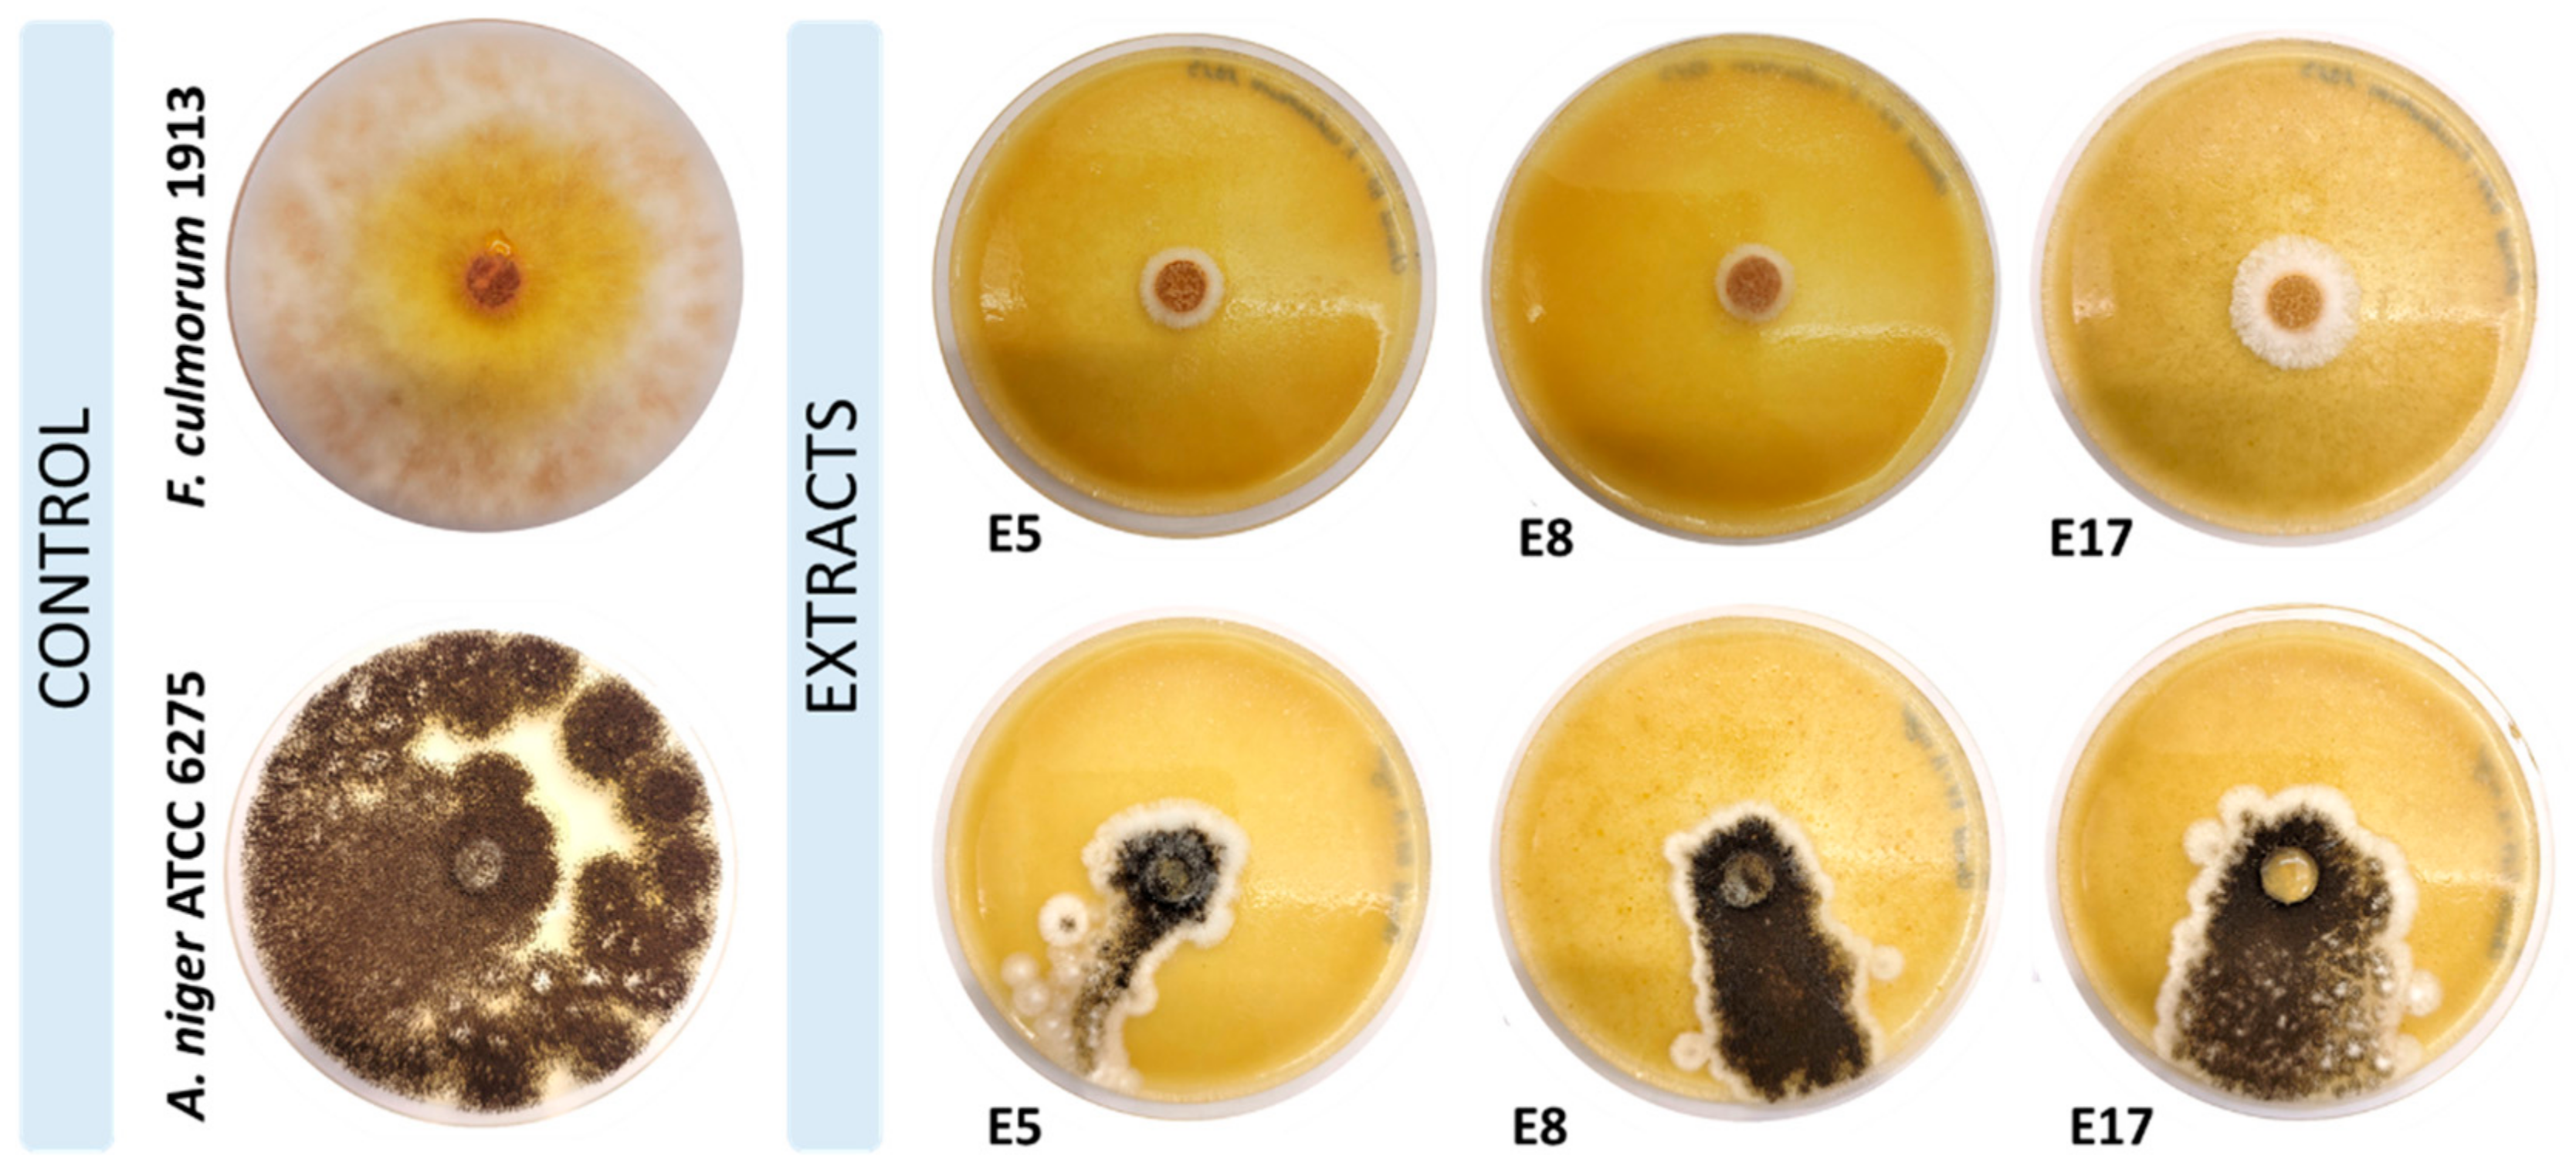

Optimization of Antifungal Properties of Hop Cone Carbon Dioxide Extracts Based on Response Surface Methodology
Abstract
1. Introduction
2. Results and Discussion
2.1. Hop Cone scCO2 Extraction
2.2. Bioactive Compounds in Hop Cone scCO2 Extracts
2.3. Antifungal Properties
3. Materials and Methods
3.1. Materials
3.1.1. Plant Collection and Sample Preparation
3.1.2. Fungal Culture Collection and Culture
3.1.3. Chemicals and Software
3.2. Methods
3.2.1. Supercritical Fluid Extraction (SFE)
3.2.2. High-Performance Liquid Chromatography (HPLC)
3.2.3. Pigment Content
3.2.4. Antifungal Properties
4. Conclusions
Author Contributions
Funding
Institutional Review Board Statement
Informed Consent Statement
Data Availability Statement
Conflicts of Interest
References
- Raiser, T. World Beer Market Achieves Growth in Challenging Times, BarthHass Report 2022/2023. Available online: https://www.barthhaas.com/fileadmin/user_upload/PR_world-beer-market_2023.pdf (accessed on 31 March 2024).
- Wood, L. Hops Extracts Market Poised for Growth: Comprehensive Industry Analysis Reveals Key Trends and Forecast to 2031; Research and Markets: Dublin, Ireland, 2024. [Google Scholar]
- Almaguer, C.; Schönberger, C.; Gastl, M.; Arendt, E.K.; Becker, T. Humulus lupulus—A story that begs to be told. A review. J. Inst. Brew. 2014, 120, 289–314. [Google Scholar] [CrossRef]
- Przybyś, M.; Skomra, U. Hops as a source of biologically active compounds. Pol. J. Agron. 2020, 43, 83–102. [Google Scholar]
- Kowalska, G.; Bouchentouf, S.; Kowalski, R.; Wyrostek, J.; Pankiewicz, U.; Mazurek, A.; Sujka, M.; Włodarczyk-Stasiak, M. The hop cones (Humulus lupulus L.): Chemical composition, antioxidant properties and molecular docking simulations. J. Herb. Med. 2022, 33, 100566. [Google Scholar] [CrossRef]
- Tyśkiewicz, K.; Gieysztor, R.; Konkol, M.; Szałas, J.; Rój, E. Essential oil from Humulus Lupulus scCO2 extract by hydrodistillation and microwave-assisted hydrodistillation. Molecules 2018, 23, 2866. [Google Scholar] [CrossRef] [PubMed]
- Franco, L.; Sánchez, C.; Bravo, R.; Rodríguez, A.B.; Barriga, C.; Romero, E. The sedative effect of non-alcoholic beer in healthy female nurses. PLoS ONE 2012, 7, e37290. [Google Scholar] [CrossRef] [PubMed]
- Miranda, C.L.; Stevens, J.F.; Helmrich, A.; Henderson, M.C.; Rodriguez, R.J.; Yang, Y.H.; Deinzer, M.L.; Barnes, D.W. Antiproliferative and cytotoxic effects of prenylated flavonoids from hops (Humulus lupulus) in human cancer cell lines. Food Chem. Toxicol. 1999, 37, 271–285. [Google Scholar] [CrossRef] [PubMed]
- Stevens, J.F.; Page, J.E. Xanthohumol and related prenylflavonoids from hops and beer: To your good health! Phytochemistry 2004, 65, 1317–1330. [Google Scholar] [CrossRef]
- Yamamoto, Y.; Gaynor, J.J.; Yu, B. Green tea catechins, cholesterol consumption, and long-term exercise are associated with delayed onset of high-fat diet-induced obesity and metabolic syndrome in rats. J. Nutr. 2016, 146, 2302–2313. [Google Scholar]
- Hartsel, J.A.; Eades, J.; Hickory, B.; Makriyannis, A. Cannabis sativa and hemp. In Nutraceuticals; Elsevier: Amsterdam, The Netherlands, 2016. [Google Scholar]
- Rufino, A.T.; Ribeiro, M.; Sousa, C.; Judas, F.; Salgueiro, L.; Cavaleiro, C.; Mendes, A.F. Evaluation of the anti-inflammatory, anti-catabolic and pro-anabolic effects of E.-caryophyllene, myrcene and limonene in a cell model of osteoarthritis. Eur. J. Pharmacol. 2015, 750, 141–150. [Google Scholar] [CrossRef] [PubMed]
- Fernandes, E.S.; Passos, G.F.; Medeiros, R.; da Cunha, F.M.; Ferreira, J.; Campos, M.M.; Pianowski, L.F.; Calixto, J.B. Anti-inflammatory effects of compounds alpha-humulene and (−)-trans-caryophyllene isolated from the essential oil of Cordia verbenacea. Eur. J. Pharmacol. 2007, 569, 228–236. [Google Scholar] [CrossRef] [PubMed]
- Zhang, Q.Q.; Lin, L.G.; Ye, W.C. Techniques for extraction and isolation of natural products: A comprehensive review. Chin. Med. 2018, 17, 20. [Google Scholar] [CrossRef] [PubMed]
- Machado, B.A.; de Abreu Barreto, G.; Costa, A.S.; Costa, S.S.; Silva, R.P.; da Silva, D.F.; Brandão, H.N.; da Rocha, J.L.; Nunes, S.B.; Umsza-Guez, M.A.; et al. Determination of parameters for the supercritical extraction of antioxidant compounds from green propolis using carbon dioxide and ethanol as co-Solvent. PLoS ONE 2015, 10, e0134489. [Google Scholar] [CrossRef]
- Fischer, B.; Gevinski, E.V.; da Silva, D.M.; Júnior, P.A.L.; Bandiera, V.J.; Lohmann, A.M.; Rigo, D.; Duarte, P.F.; Franceschi, E.; Zandoná, G.P.; et al. Extraction of hops pelletized (Humulus lupulus) with subcritical CO2 and hydrodistillation: Chemical composition identification, kinetic model, and evaluation of antioxidant and antimicrobial activity. Food Res. Int. 2023, 167, 112712. [Google Scholar] [CrossRef] [PubMed]
- Vichi, S. Extraction techniques for the analysis of virgin olive oil aroma. In Olives and Olive Oil in Health and Disease Prevention; Preedy, V.R., Watson, R.R., Eds.; Academic Press: Cambridge, MA, USA, 2010. [Google Scholar]
- Olsovska, J.; Bostikova, V.; Dusek, M.; Jandovska, V.; Bogdanova, K.; Cermak, P.; Bostik, P.; Mikyska, A.; Kolar, M. Humulus lupulus L. (hops)—A valuable source of compounds with bioactive effects for future therapies. Mil. Med. Sci. Lett. 2016, 85, 19–30. [Google Scholar] [CrossRef]
- Radzali, S.A.; Markom, M.; Saleh, N.M. Parameters effects and optimisation in supercritical fluid extraction of phenolic compounds form Labisia pumila. Separations 2022, 9, 385. [Google Scholar] [CrossRef]
- Sharif, K.M.; Rahman, M.M.; Azmir, J.; Mohamed, A.; Jahurul, M.H.A.; Sahena, F.; Zaidul, I.S.M. Experimental design of supercritical fluid extraction—A review. J. Food Eng. 2014, 124, 105–116. [Google Scholar] [CrossRef]
- Vafaei, N.; Rempel, C.B.; Scanlon, M.G.; Jones, P.J.H.; Eskin, M.N.A. Application of supercritical fluid extraction (SFE) of tocopherols and carotenoids (hydrophobic antioxidants) compared to non-SFE methods. App. Chem. 2022, 2, 68–92. [Google Scholar] [CrossRef]
- Pfaf-Šovljanski, I.I.; Grujić, O.S.; Peruničić, M.B.; Cvetković, I.M.; Zeković, Z.P. Supercritical carbon dioxide hop extraction. Acta Period. Technol. 2005, 35, 111–121. [Google Scholar] [CrossRef]
- Zeković, Z.; Pfaf-Šovljanski, I.; Grujić, O. Supercritical fluid extraction of hops. J. Serb. Chem. Soc. 2007, 72, 81–87. [Google Scholar] [CrossRef]
- Nagybákay, N.E.; Syrpas, M.; Vilimaitė, V.; Tamkutė, L.; Pukalskas, A.; Venskutonis, P.R.; Kitrytė, V. Optimized supercritical CO2 extraction enhances the recovery of valuable lipophilic antioxidants and other consitutents from dual-purpose hop (Humulus lupulus L.) variety Ella. Antioxidants 2021, 10, 918. [Google Scholar] [CrossRef]
- Kupski, S.C.; Klein, E.J.; da Silva, E.A.; Palú, F.; Guirardllo, R.; Vieira, M.G.A. Mathematical modeling of supercritical CO2 extraction of hops (Humulus lupulus L.). J. Supercrit. Fluid. 2017, 130, 347–356. [Google Scholar] [CrossRef]
- Rój, E.; Tadić, V.M.; Mišić, D.; Žižović, I.; Arsić, I.; Dobrzyńska-Inger, A.; Kostrzewa, D. Supercritical carbon dioxide hops extracts with antimicrobial properties. Open Chem. 2015, 13, 1157–1171. [Google Scholar] [CrossRef]
- Del Valle, J.M.; Rivera, O.; Teuber, O.; Palma, M.T. Supercritical CO2 extraction of Chilean hop (Humulus lupulus) ecotypes. J. Sci. Food Agric. 2003, 83, 1349–1356. [Google Scholar] [CrossRef]
- He, G.; Xiong, H.; Chen, Q.; Ruan, H.; Wang, Z.; Traoré, L. Optimization of conditions for supercritical fluid extraction of flavonoids from hops (Humulus lupulus L.). J. Zhejiang Univ.-Sci. B 2005, 6, 999–1004. [Google Scholar] [CrossRef] [PubMed]
- Dzingelevičius, N.; Maruška, A.; Ragažinskienė, O.; Obelevičius, K. Optimization of hop essential oil extraction by means of supercritical CO2. Biologija 2011, 57, 63–69. [Google Scholar] [CrossRef][Green Version]
- Bizaj, K.; Škerget, M.; Košir, I.; Knez, Ž. Sub- and supercritical extraction of Slovenian hops (Humulus lupulus L.) Aurora variety using different solvents. Plants 2021, 10, 1137. [Google Scholar] [CrossRef] [PubMed]
- Schoss, K.; Kočevar, G.N.; Dolenc, K.J.; Anžlovar, S. Supercritical CO2 plant extracts show antifungal activities against crop-borne fungi. Molecules 2022, 27, 1132. [Google Scholar] [CrossRef] [PubMed]
- Du, T.; Shupe, T.F.; Hse, C.Y. Antifungal activities of three supercritical fluid extracted cedar oils. Holzforschung 2011, 65, 277–284. [Google Scholar] [CrossRef]
- Tyśkiewicz, K.; Tyśkiewicz, R.; Konkol, M.; Rój, E.; Jaroszuk-Ściseł, J.; Skalicka-Woźniak, K. Antifungal properties of Fucus vesiculosus L. supercritical fluid extract against Fusarium culmorum and Fusarium oxysporum. Molecules 2019, 24, 3518. [Google Scholar] [CrossRef]
- Bai, X.; Cheng, J.; Liang, W.; Ma, L.; Liu, Y.; Shi, G.; Wang, Y. Antifungal activity of extracts by supercritical carbon dioxide extraction from roots of Stellera chamaejasme L. and analysis of their constituents using GC-MS. In Information Technology and Agricultural Engineering; Zhu, E., Sambath, S., Eds.; Advances in Intelligent and Soft Computing; Springer: Berlin/Heidelberg, Germany, 2012. [Google Scholar]
- Alonso-Esteban, J.I.; Pinela, J.; Barros, L.; Ćirić, A.; Soković, M.; Calhelha, R.C.; Torija-Isasa, E.; de Cortes Sánchez-Mata, M.; Ferreira, I.C.F.R. Phenolic composition and antioxidant, antimicrobial and cytotoxic properties of hop (Humulus lupulus L.) seeds. Ind. Crops Prod. 2019, 134, 154–159. [Google Scholar] [CrossRef]
- Nionelli, L.; Pontonio, E.; Gobbetti, M.; Rizzello, C.G. Use of hop extract as antifungal ingredient for bread making and selection of autochthonous resistant starters for sourdough fermentation. Int. J. Food Microbiol. 2018, 266, 173–182. [Google Scholar] [CrossRef] [PubMed]
- Bartmańska, A.; Wałecka-Zacharska, E.; Tronina, T.; Popłoński, J.; Sordon, S.; Brzezowska, E.; Bania, J.; Huszcza, E. Antimicrobial properties of spent hops extracts, flavonoids isolated therefrom, and their derivatives. Molecules 2018, 23, 2059. [Google Scholar] [CrossRef] [PubMed]
- Avalos, J.; Carmen Limón, M. Biological Roles of Fungal Carotenoids. Curr. Genet. 2015, 61, 309–324. [Google Scholar] [CrossRef] [PubMed]
- Naz, T.; Ullah, S.; Nazir, Y.; Li, S.; Iqbal, B.; Liu, Q.; Mohamed, H.; Song, Y. Industrially Important Fungal Carotenoids: Advancements in Biotechnological Production and Extraction. J. Fungi. 2023, 9, 578. [Google Scholar] [CrossRef] [PubMed]
- Mezghanni, H.; Khedler, S.B.; Tousni, S.; Zouari, N. Medium optimization of antifungal activity production by Bacillus amyloliquefaciens using statistical experiment design. Prep. Biochem. Biotech. 2012, 42, 267–278. [Google Scholar] [CrossRef] [PubMed]
- Mares Castro, A.; Estrada Monje, A.; Saldívar Campos, A.I.; Zaragoza Estrada, A. Optimization of the Antifungal Property in a Composite of Polyurethane and Silver Nanoparticles against the Trichophyton rubrum Fungus. Appl. Sci. 2023, 13, 12028. [Google Scholar] [CrossRef]
- El-Housseiny, G.S.; Shams, G.; Ghobashi, Z.; Mamdouh, R.; Almaqsod, I.; Saleh, S. Optimization of antifungal activity by Bacillus subtilis isolate CCASU 2021-4 using response surface methodology. Arch. Pharm. Sci. Ain Shams Univ. 2021, 5, 171–183. [Google Scholar] [CrossRef]
- Gharbani, P.; Jam, N.; Doshmanfekan, H.; Mehrizad, A. Optimization of synergic antibacterial activity of Punica granatum L. and Areca nut (P.G.L.A.N) extracts through response surface methodology. Sci. Rep. 2023, 13, 6098. [Google Scholar] [CrossRef] [PubMed]
- Chen, C.; Wan, C.; Peng, X.; Chen, Y.; Chen, M.; Chen, J. Optimization of Antifungal Extracts from Ficus hirta Fruits Using Response Surface Methodology and Antifungal Activity Tests. Molecules 2015, 20, 19647–19659. [Google Scholar] [CrossRef] [PubMed]
- Pereira, P.; Bernardo-Gil, M.G.; Cebola, M.J.; Mauricio, E.; Romano, A. Supercritical fluid extracts with antioxidant and antimicrobial activities from myrtle (Myrtus communis L.) leaves. Response surface optimization. J. Supercrit. Fluid. 2013, 83, 57–64. [Google Scholar] [CrossRef]
- Lichtenthaler, H. Determination of total carotenoids and chlorophylls a and b of leaf in different solvents. Methods Enzymol. 1987, 148, 350–382. [Google Scholar] [CrossRef]
- Dere, Ş.; Güneş, T.; Sivaci, R. Spectrophotometric determination of chlorophyll—A, B and total carotenoid contents of some algae species using different solvents. Tr. J. Bot. 1998, 22, 13–17. [Google Scholar]

| Exp. | Temperature, °C | Pressure, Bar | CO2 Consumption, kgCO2/kg | Extraction Yield, wt% | |||
|---|---|---|---|---|---|---|---|
| U | C | U | C | U | C | ||
| 1 | 40 | −1 | 300 | 1 | 50 | 0 | 12.83 |
| 2 | 50 | 0 | 250 | 0 | 50 | 0 | 12.09 |
| 3 | 50 | 0 | 200 | −1 | 25 | −1 | 9.88 |
| 4 | 60 | 1 | 250 | 0 | 25 | −1 | 10.87 |
| 5 | 40 | −1 | 250 | 0 | 25 | −1 | 9.21 |
| 6 | 40 | −1 | 250 | 0 | 75 | 1 | 13.21 |
| 7 | 60 | 1 | 250 | 0 | 75 | 1 | 13.89 |
| 8 | 50 | 0 | 200 | −1 | 75 | 1 | 10.47 |
| 9 | 50 | 0 | 250 | 0 | 50 | 0 | 13.47 |
| 10 | 60 | 1 | 200 | −1 | 50 | 0 | 12.28 |
| 11 | 50 | 0 | 300 | 1 | 75 | 1 | 16.23 |
| 12 | 50 | 0 | 250 | 0 | 50 | 0 | 11.19 |
| 13 | 50 | 0 | 250 | 0 | 50 | 0 | 10.31 |
| 14 | 60 | 1 | 300 | 1 | 50 | 0 | 11.34 |
| 15 | 40 | −1 | 200 | −1 | 50 | 0 | 10.08 |
| 16 | 50 | 0 | 300 | 1 | 25 | −1 | 12.09 |
| 17 | 50 | 0 | 250 | 0 | 50 | 0 | 12.94 |
| Exp. | Cohumulone | N + Adhumulone | Colupulone | N + Adlupulone | Sum of α-Acids | Sum of β-Acids | Sum of Bitter Acids |
|---|---|---|---|---|---|---|---|
| wt% | |||||||
| 1 | 8.65 ± 0.23 | 28.33 ± 0.11 | 10.39 ± 0.11 | 9.88 ± 0.05 | 36.98 ± 0.03 | 20.27 ± 0.04 | 57.25 ± 0.03 |
| 2 | 8.46 ± 0.21 | 27.79 ± 0.08 | 10.12 ± 0.05 | 9.55 ± 0.03 | 36.25 ± 0.04 | 19.67 ± 0.03 | 55.92 ± 0.09 |
| 3 | 8.58 ± 0.15 | 27.36 ± 0.08 | 10.73 ± 0.03 | 10.35 ± 0.02 | 35.94 ± 0.09 | 21.08 ± 0.11 | 57.02 ± 0.10 |
| 4 | 7.26 ± 0.11 | 23.75 ± 0.12 | 9.01 ± 0.05 | 8.57 ± 0.04 | 31.01 ± 0.00 | 17.58 ± 0.03 | 48.59 ± 0.23 |
| 5 | 7.68 ± 0.05 | 25.13 ± 0.02 | 9.90 ± 0.09 | 9.53 ± 0.03 | 32.81 ± 0.04 | 19.43 ± 0.04 | 52.24 ± 0.04 |
| 6 | 8.38 ± 0.09 | 27.22 ± 0.01 | 10.08 ± 0.12 | 9.62 ± 0.01 | 35.60 ± 0.10 | 19.70 ± 0.06 | 55.30 ± 0.05 |
| 7 | 7.42 ± 0.12 | 24.24 ± 0.01 | 8.84 ± 0.20 | 8.37 ± 0.05 | 31.66 ± 0.06 | 17.21 ± 0.06 | 48.87 ± 0.05 |
| 8 | 7.62 ± 0.02 | 24.95 ± 0.02 | 9.58 ± 0.05 | 9.15 ± 0.05 | 32.57 ± 0.08 | 18.73 ± 0.04 | 51.30 ± 0.12 |
| 9 | 8.25 ± 0.03 | 26.93 ± 0.04 | 9.97 ± 0.00 | 9.59 ± 0.06 | 35.18 ± 0.01 | 19.56 ± 0.03 | 54.74 ± 0.11 |
| 10 | 8.02 ± 0.12 | 26.04 ± 0.11 | 10.03 ± 0.01 | 9.67 ± 0.08 | 34.06 ± 0.01 | 19.70 ± 0.02 | 53.76 ± 0.10 |
| 11 | 8.21 ± 0.32 | 26.77 ± 0.12 | 9.32 ± 0.02 | 8.72 ± 0.01 | 34.98 ± 0.01 | 18.04 ± 0.02 | 53.02 ± 0.07 |
| 12 | 8.19 ± 0.11 | 26.37 ± 0.14 | 10.04 ± 0.13 | 9.64 ± 0.02 | 34.56 ± 0.02 | 19.68 ± 0.01 | 54.24 ± 0.08 |
| 13 | 8.38 ± 0.01 | 27.06 ± 0.32 | 10.24 ± 0.12 | 9.83 ± 0.02 | 35.44 ± 0.02 | 20.07 ± 0.12 | 55.51 ± 0.05 |
| 14 | 8.45 ± 0.12 | 27.34 ± 0.01 | 10.37 ± 0.00 | 9.91 ± 0.01 | 35.79 ± 0.05 | 20.28 ± 0.03 | 56.07 ± 0.03 |
| 15 | 8.50 ± 0.21 | 27.53 ± 0.03 | 10.81 ± 0.00 | 10.28 ± 0.02 | 36.03 ± 0.05 | 21.09 ± 0.02 | 57.12 ± 0.12 |
| 16 | 8.62 ± 0.05 | 28.04 ± 0.02 | 10.38 ± 0.11 | 9.83 ± 0.01 | 36.66 ± 0.02 | 20.21 ± 0.05 | 56.87 ± 0.10 |
| 17 | 8.38 ± 0.04 | 27.52 ± 0.11 | 10.27 ± 0.05 | 9.76 ± 0.03 | 35.90 ± 0.00 | 20.03 ± 0.05 | 55.93 ± 0.09 |
| Exp. | Chlorophyll A, mg/kg | Chlorophyll B, mg/kg | Carotenoids, mg/kg |
|---|---|---|---|
| 1 | 81.59 ± 0.00 | 77.21 ± 0.01 | 65.81 ± 4.66 |
| 2 | 85.48 ± 0.05 | 64.24 ± 0.00 | 57.26 ± 0.18 |
| 3 | 41.24 ± 0.05 | 49.22 ± 0.01 | 25.86 ± 0.35 |
| 4 | 60.45 ± 0.00 | 69.75 ± 0.02 | 56.87 ± 5.36 |
| 5 | 45.98 ± 0.00 | 64.22 ± 0.02 | 39.97 ± 6.45 |
| 6 | 78.67 ± 0.00 | 93.60 ± 0.01 | 94.65 ± 2.19 |
| 7 | 56.16 ± 0.04 | 61.90 ± 0.01 | 39.22 ± 0.46 |
| 8 | 43.10 ± 0.00 | 57.99 ± 0.00 | 41.32 ± 3.47 |
| 9 | 61.58 ± 0.06 | 64.29 ± 0.02 | 48.10 ± 0.19 |
| 10 | 38.41 ± 0.03 | 49.62 ± 0.00 | 26.15 ± 0.65 |
| 11 | 178.92 ± 0.05 | 135.03 ± 0.01 | 167.86 ± 0.38 |
| 12 | 53.90 ± 0.00 | 77.82 ± 0.01 | 52.88 ± 4.89 |
| 13 | 60.93 ± 0.05 | 75.89 ± 0.00 | 67.90 ± 0.29 |
| 14 | 55.04 ± 0.00 | 77.60 ± 0.02 | 59.74 ± 6.84 |
| 15 | 49.63 ± 0.02 | 67.35 ± 0.01 | 46.97 ± 0.11 |
| 16 | 129.94 ± 0.01 | 155.36 ± 0.02 | 153.79 ± 8.84 |
| 17 | 116.48 ± 0.04 | 105.10 ± 0.01 | 135.63 ± 0.23 |
| Exp. | SFE Parameters (Temperature, °C; Pressure, Bar; CO2 Consumption, kgCO2/kg) | F. culmorum 1913 Growth Inhibition, % ± SD | A. niger ATCC 6275 Growth Inhibition, % ± SD |
|---|---|---|---|
| 1 | 40, 300, 50 | 84 ± 2 | 56 ± 2 |
| 2 | 50, 250, 50 | 73 ± 2 | 51 ± 3 |
| 3 | 50, 200, 25 | 81 ± 1 | 53 ± 3 |
| 4 | 60, 250, 25 | 81 ± 1 | 50 ± 2 |
| 5 | 40, 250, 25 | 81 ± 0 | 52 ± 3 |
| 6 | 40, 250, 75 | 78 ± 1 | 54 ± 2 |
| 7 | 60, 250, 75 | 84 ± 1 | 63 ± 2 |
| 8 | 50, 200, 75 | 100 ± 0 | 68 ± 2 |
| 9 | 50, 250, 50 | 72 ± 1 | 52 ± 3 |
| 10 | 60, 200, 50 | 93 ± 1 | 62 ± 1 |
| 11 | 50, 300, 75 | 65 ± 1 | 56 ± 4 |
| 12 | 50, 250, 50 | 74 ± 1 | 48 ± 3 |
| 13 | 50, 250, 50 | 73 ± 1 | 52 ± 3 |
| 14 | 60, 300, 50 | 84 ± 1 | 39 ± 3 |
| 15 | 40, 200, 50 | 91 ± 2 | 58 ± 1 |
| 16 | 50, 300, 25 | 75 ± 2 | 47 ± 1 |
| 17 | 50, 250, 50 | 72 ± 1 | 45 ± 0 |
Disclaimer/Publisher’s Note: The statements, opinions and data contained in all publications are solely those of the individual author(s) and contributor(s) and not of MDPI and/or the editor(s). MDPI and/or the editor(s) disclaim responsibility for any injury to people or property resulting from any ideas, methods, instructions or products referred to in the content. |
© 2024 by the authors. Licensee MDPI, Basel, Switzerland. This article is an open access article distributed under the terms and conditions of the Creative Commons Attribution (CC BY) license (https://creativecommons.org/licenses/by/4.0/).
Share and Cite
Tyśkiewicz, K.; Tyśkiewicz, R.; Konkol, M.; Gruba, M.; Kowalski, R. Optimization of Antifungal Properties of Hop Cone Carbon Dioxide Extracts Based on Response Surface Methodology. Molecules 2024, 29, 2554. https://doi.org/10.3390/molecules29112554
Tyśkiewicz K, Tyśkiewicz R, Konkol M, Gruba M, Kowalski R. Optimization of Antifungal Properties of Hop Cone Carbon Dioxide Extracts Based on Response Surface Methodology. Molecules. 2024; 29(11):2554. https://doi.org/10.3390/molecules29112554
Chicago/Turabian StyleTyśkiewicz, Katarzyna, Renata Tyśkiewicz, Marcin Konkol, Marcin Gruba, and Rafał Kowalski. 2024. "Optimization of Antifungal Properties of Hop Cone Carbon Dioxide Extracts Based on Response Surface Methodology" Molecules 29, no. 11: 2554. https://doi.org/10.3390/molecules29112554
APA StyleTyśkiewicz, K., Tyśkiewicz, R., Konkol, M., Gruba, M., & Kowalski, R. (2024). Optimization of Antifungal Properties of Hop Cone Carbon Dioxide Extracts Based on Response Surface Methodology. Molecules, 29(11), 2554. https://doi.org/10.3390/molecules29112554

